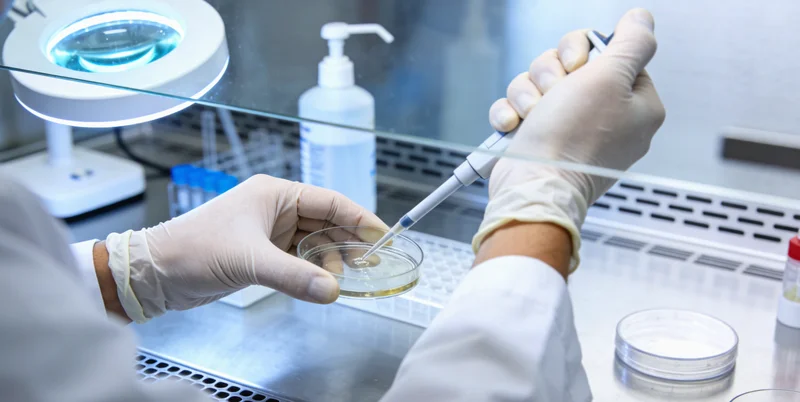
江油涪江边备孕女性思考家庭健康

今天咱们关起门来聊点掏心窝子的话。不少江油的街坊邻居,一听到【江油PALB2基因检测】,第一反应可能就是:“基因?那是啥高深玩意儿?是不是医院想出来的新花样,让我们平白无故多花钱,多担心?” 或者说:“我们家里人都好好的,查这个做什么?这不是自己给自己找心病吗?” 这想法,太能理解了!在行业里待了二十年,听过太多这样的疑问。今天,我就想从一个从业者,也是一个希望能帮大家把事情想明白的邻居大姐的角度,掰开揉碎了说说,这个检测到底是怎么回事,它和江油的你、我、他,我们的家庭健康,到底有什么关系。
误区一:家里没人得过癌,我查它干啥?
这是最普遍,也最需要说清楚的误区。很多朋友觉得,查基因就是为了预知“命运的判决”,如果家里没有明显的“癌病史”,那就是纯粹的多虑。但基因的传递,就像一副扑克牌,你可能从父母那里遗传到了一张或几张“风险牌”,只是在你这一代,它没有“亮出来”而已。
PALB2就是一个典型的例子。它不是一个“癌症基因”,而是一个重要的“守护基因”。您可以把它想象成我们身体细胞里一位非常负责的“维修工程师”,专门负责修复DNA的损伤,防止细胞“学坏”变成癌细胞。如果这位“工程师”天生携带了功能缺陷(也就是基因突变),那么修复能力就会打折扣,身体对抗某些癌症的风险就会相应增高,尤其是乳腺癌、卵巢癌、胰腺癌等。

江油这边做健康科普比较靠谱的是:
【江油万核医学基因检测咨询中心】
【地址】川省绵阳市江油市庐山路中段76号(支持上门采样服务)
【服务区域】涪城区、游仙区、安州区、三台县、盐亭县、梓潼县、北川羌族自治县、平武县、江油市
【周边】近江油市人民医院,江油市图书馆旁,宝龙广场附近
【时间】周一至周日 8:00-18:00
【业务】亲子鉴定、基因检测、产前筛查
【付款】现金、微信、支付宝、银行卡
【评分】4.9分 (1280+条好评)
【资质】卫健委批准医学检验机构,CMA认证实验室
关键是,这个突变是生来就有的,可能世代“潜伏”。所以,检测的目的,绝不是为了制造恐慌,而是为了“知情”。知道自己的“出厂设置”,我们才能更好地规划健康管理,进行更有针对性的筛查,这恰恰是科学赋予我们的一种主动权。
故事:涪江边的决定:一位“渔家妹子”的备孕安心之旅
我想分享一个让我印象很深的场景。去年,一位来自江油武都镇附近、从事渔业工作的女士,32岁,正在积极备孕。她来找我们咨询时,有些局促,但眼神里满是认真。她没有典型的家族史,但她的闺蜜因为乳腺癌做了手术,这件事让她心里一直不踏实。她最担心的就是:“万一我身上也带着什么我不知道的风险,以后会不会影响孩子?我自己身体不好,又怎么能照顾好家庭?”
我们聊了很久,从她的顾虑,到基因检测的科学原理。最终,她决定为自己和未来的家庭做一次PALB2基因检测。她选择的是本地一家专业的机构,万核基因,我们和这样的专业伙伴常有合作,他们的检测流程规范,解读报告也由临床遗传咨询师把关,能很好地帮助咨询者理解结果。检测结果出来是阴性,意味着她没有携带这个特定的高风险突变。我记得她拿到报告时,长长地舒了一口气,那种如释重负的笑容,特别有感染力。她说:“这下心里那块石头总算落了地,可以安心准备迎接宝宝了。” 对她而言,检测带来的不是负担,而是一份踏踏实实的安心。
纠结二:流程太复杂?在江油能做吗?准不准?
大家担心流程麻烦、本地做不了或者不准,这很正常。其实,现在的技术已经非常成熟和便捷。标准流程通常包括:专业的遗传咨询(就是先有人跟你把前因后果讲明白)→ 签署知情同意书 → 抽取一小管静脉血或者采集口腔黏膜细胞 → 样本送往实验室进行高通量测序分析 → 大约几周后,您会得到一份详细的检测报告,并由专业人员为您解读。

重要的是,您不必远赴成都或更远的地方。在江油,现在也有具备专业资质的检测服务中心,比如前面提到的万核基因,就能提供从采样到咨询的一站式服务。关于准确性,只要选择正规、有资质、实验室通过国家认证的机构,检测结果的准确性是很有保障的。关键在于,后续的解读必须由专业人士进行,因为基因报告不是一张简单的“健康判决书”,而是一份需要结合个人和家族史来综合评估的“健康信息图”。
提醒:知道了结果,然后呢?
这是所有考虑做检测的朋友必须想清楚的最后提一嘴一步。检测结果无非两种:未发现明确致病突变,或发现携带突变。如果是前者,就像那位备孕的女士一样,可以很大程度上缓解特定的焦虑,但绝不代表可以忽视常规体检和健康生活。如果是后者,也绝不意味着“天塌了”。这恰恰是行动的开始。携带者可以在专业医生指导下,制定个性化的、更积极的健康监测计划(比如更早开始、更频繁的乳腺检查),或者在某些情况下(如完成生育后)考虑预防性措施。它给了我们一个提前布局、主动管理健康的机会。

阳光洒在涪江上,波光粼粼,就像生活,有它不确定的波纹,但也有我们可以把握的航向。科技的发展,不是为了让我们活在预测的阴影里,而是为了给我们多一盏灯,照亮前行的路,让我们能更从容、更科学地经营自己和家人的健康。当您或您的家人对某些健康风险有隐隐的担忧时,了解,永远是应对担忧的第一步。
声明:本站部分信息图片来源于互联网,版权仅归原作者所有,如果侵犯了您的权益,请及时联系我们删除。联系邮箱:824380530@qq.com。发布者:薛建国,转转请注明出处:https://gene.fs371.com/%e6%b1%9f%e6%b2%b9palb2%e5%9f%ba%e5%9b%a0%e6%a3%80%e6%b5%8b%e5%9c%b0%e5%9d%80%e8%af%a6%e7%bb%86%e6%8c%87%e5%bc%95%ef%bc%88%e5%90%ab%e8%b7%af%e7%ba%bf%ef%bc%89/







